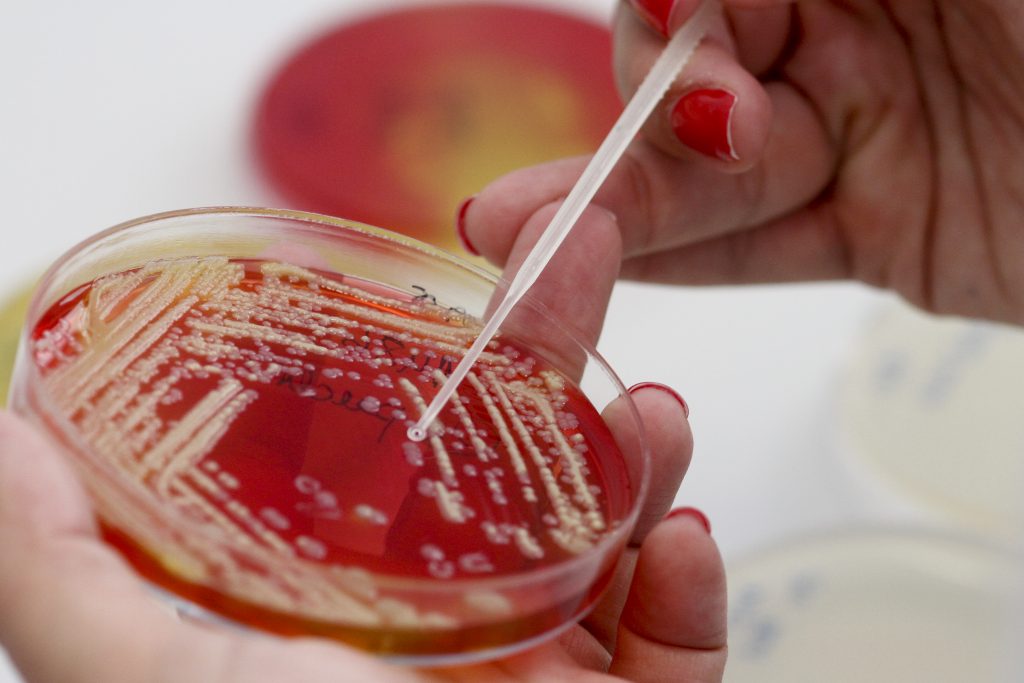

A comemorar 40 anos de atividade, o Laboratório dos Serviços Municipalizados de Água e Saneamento de Sintra (SMAS de Sintra) conquistou recentemente um reforço de peso, um robô para análises físico-químicas, que permite a realização de ensaios de forma totalmente autónoma, incluindo a preparação das amostras. Representando um investimento de cerca de 100 mil euros, este robô de laboratório, AP3900, permite realizar análises dos parâmetros de carência química de oxigénio (CQO), azoto total, fósforo total, azoto amoniacal, nitritos e nitratos. O novo equipamento representa uma mais-valia para os serviços que realiza análises de variada índole, como águas de abastecimento, captações, águas residuais, lamas de ETAR, pontos Ecoágua, águas balneares, ribeiras e piscinas.
O mais recente investimento do Laboratório dos SMAS de Sintra foi desvendado durante uma comunicação, da autoria de Andreia Pires, Carla Sobral, Célia Luz e Marta Lopes, apresentada no Encontro Nacional de Entidades Gestoras de Água e Saneamento (ENEG 2025), que está a decorrer no Europarque, em Santa Maria da Feira.
- Comunicação no ENEG 2025 sobre o Laboratório dos SMAS de Sintra
- Técnica superior do Laboratório dos SMAS de Sintra, Marta Lopes
A aquisição do robô vai permitir melhorar o tempo de resposta aos clientes, dado o volume de trabalho do serviço, que efetuou a análise, em 2024, de quase seis mil amostras, que se dividiram entre águas limpas (abastecimento de água e captações) e as provenientes do controlo das 18 estações de tratamento de águas residuais (ETAR) que abrangem o sistema de saneamento do concelho.
Este novo equipamento será, assim, um precioso auxiliar para a atividade quotidiana do Laboratório dos SMAS de Sintra, que tem como principal missão o controlo da qualidade da água distribuída na rede pública e dos critérios legalmente fixados. Para esse efeito, é elaborado, anualmente, um Programa de Controlo de Qualidade da Água (PCQA), submetido à aprovação da Entidade Reguladora dos Serviços de Águas e Resíduos (ERSAR), que corresponde às análises efetuadas nas torneiras do consumidor e que se irá traduzir, em 2025, em 1.045 colheitas. Paralelamente, é efetuado um controlo operacional em vários pontos da rede de abastecimento de água, como nas captações próprias dos SMAS, na entrega de água ao concelho (por parte da EPAL), nos reservatórios (para controlar a higienização dos mesmos) e na própria rede de distribuição, que corresponde a 1.284 colheitas.
O controlo das águas residuais é efetuado, por seu turno, à entrada das ETAR, em órgãos das unidades de tratamento para eventual ajuste do tratamento, às águas residuais tratadas, nos pontos de descarga, para dar cumprimento às licenças de descarga, no meio recetor e às lamas produzidas nas ETAR.
O Laboratório dos SMAS de Sintra tem registado, ainda, um aumento de 18% na recolha de amostras de clientes externos, sejam análises de águas de captação (furos e poços), piscinas e residuais industriais, tendo como clientes, neste último caso, inúmeras unidades industriais do concelho. Além de colheitas e análises de autocontrolo, a solicitação das empresas, o Laboratório dos SMAS de Sintra também realiza análises de amostras resultantes das ações de fiscalização às descargas industriais, garantindo que as empresas cumprem a legislação relativa às águas residuais que produzem, e monitoriza ainda a qualidade das águas afluentes ao sistema multimunicipal de saneamento de Lisboa e Vale do Tejo (Águas do Tejo Atlântico).
Criado em 1985, com a missão de controlar a qualidade microbiológica da água distribuída para consumo humano, o Laboratório dos SMAS de Sintra foi alargando, ao longo do tempo, as suas atribuições ao controlo de qualidade e análise de parâmetros físico-químicos. Em 2008, passou a estar acreditado pelo Instituto Português de Acreditação (IPAC) segundo a Norma EN ISO/IEC 17025, integrando assim a lista de laboratórios reconhecidos pela ERSAR, Es6te serviço está acreditado, atualmente, para 77 métodos analíticos, para águas de consumo, naturais doces e salinas, piscinas, residuais, lamas e a colheita de águas de consumo e naturais.
Nos últimos anos, a acreditação do IPAC foi estendida a novos parâmetros, inclusive de Legionella, e com extensão ainda para a colheita de potássio, cloritos e cloratos e para a matriz de águas residuais do parâmetro turvação, assim como a “amostras sólidas ambientais”, como resíduos, lamas, solos e outros sedimentos.